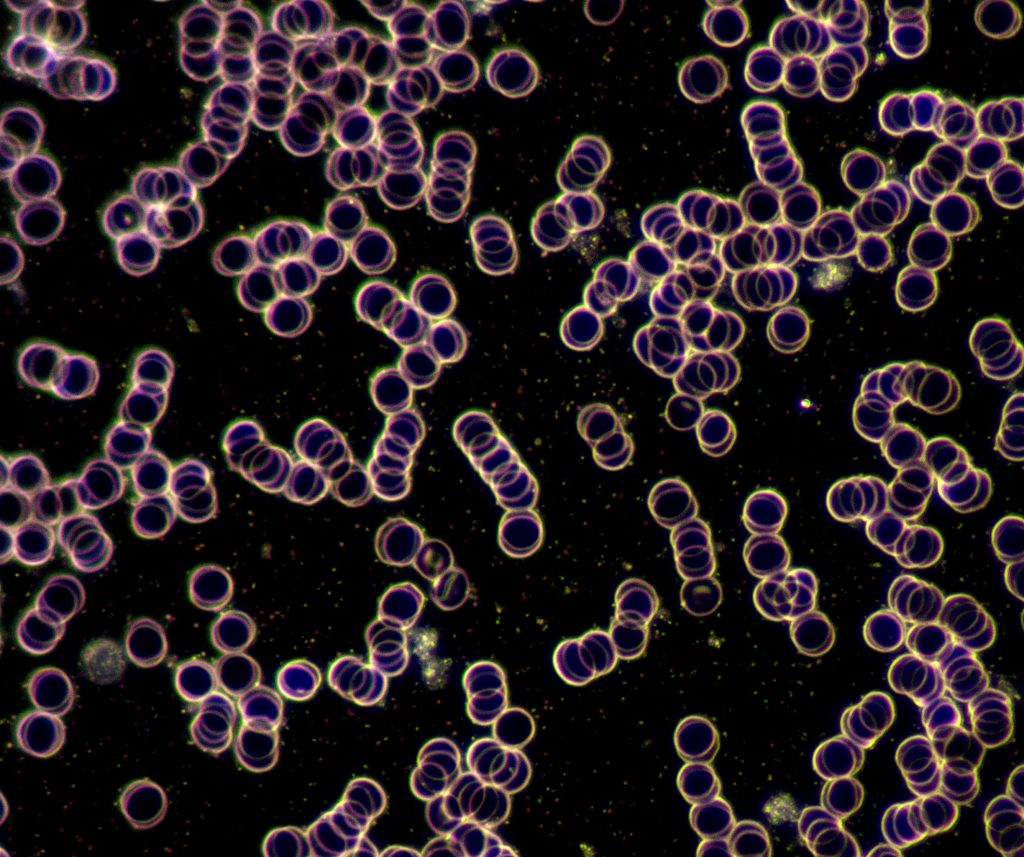

MAGNETFELDTHERAPIE (GEFÄßTHERAPIE) von BEMER
Die neue Generation Gesundheit
Du möchtest im Hobby- oder Profisport Höchstleistungen erreichen, schmerzfrei leben, belastbar und kraftvoll berufliche Herausforderungen meistern und/oder das Alter genießen? Die Magnetfeldtherapie (Gefäßtherapie) von BEMER unterstützt dich bei deinem Ziel, denn sie kann die eingeschränkte Durchblutung in deinen kleinen und kleinsten Blutgefäßen durch den Einsatz von Frequenzen verbessern – und das auf Knopfdruck. So hat dein Körper die Möglichkeit, seine Aufgaben wieder optimal zu erfüllen und zu regenerieren. Außerdem kann die Magnetfeldtherapie deinem Organismus dabei helfen, kleine Verletzungen zu reparieren und Energiereserven aufzubauen.
Mehr Fitness, mehr vom Leben
Sport bedeutet für jeden etwas anderes. Doch egal, ob man etwas für sich tun will, ambitioniert trainiert oder Profisportler ist: die Mechanismen im Körper ähneln einander. In jedem Fall gehört eine gute Regeneration zum Sport wie das Training selbst. Lass die Magnetfeldtherapie (Gefäßtherapie) von BEMER zu deinem persönlichen Trainingspartner werden! Durch die Anwendung kann die eingeschränkte Mikrozirkulation verbessert werden, die bei vielen Prozessen im Körper eine überaus wichtige Rolle spielt – sowohl nach dem Sport als auch bei Muskelkater oder Sportverletzungen.
Schmerzen? Nein, danke!
Schmerzen im Rücken, in den Gelenken oder den Muskeln können das Leben zur Qual machen. Oft sind sie die Folge einer eingeschränkten Mikrozirkulation. Die Magnetfeldtherapie (Gefäßtherapie) von BEMER setzt genau dort an. Durch ihr Potenzial, zur Verbesserung der eingeschränkten Durchblutung deiner Gefäße beizutragen, kann die Anwendung bei der Regeneration helfen und deine Selbstheilungskräfte unterstützen. Studien belegen zudem viele positive Effekte: So wurden durch die Magnetfeldtherapie (Gefäßtherapie) besonders bei Kreuzschmerzen / Schmerzen im unteren Rücken lindernde Auswirkungen verzeichnet. Auch die Ergebnisse bestimmter Therapieformen zeigten eine Verbesserung.
Leistungsfähig in Beruf und Alter
Das Leben zwischen Familie, Beruf und Alltag kann eine echte Herausforderung sein. Umso mehr, wenn es Körper und Geist nicht mehr gelingt, den Stress hinter sich zu lassen und sich in der Nacht umfassend zu erholen. Durch die Magnetfeldtherapie (Gefäßtherapie) von BEMER kann Abhilfe geschaffen werden – sowohl körperlich als auch mental. Der Grund: die Anwendung kann deine eingeschränkte Durchblutung stimulieren, welche bei vielen physiologischen Prozessen im Körper eine wichtige Rolle spielt, unter anderem bei Erholung, Schlaf und Regeneration.

Die oberen Aufnahmen zeigen menschliches Blut, das bei einer Dunkelfeldmikroskopie von Dipl. Ing. Reinhard Förster vor und nach einer Behandlung mit der Magnetfeldtherapie (Gefäßtherapie) untersucht wurde. Der Vorher-Nachher-Vergleich erfolgte nach 8 Minuten Behandlung auf einer Magnetfeldmatte. Die zunächst klümpchenhaft wirkenden Blutkörperchen schwimmen auf dem rechten Bild (nach der Behandlung) bereits deutlich freier und weniger zusammengeballt als auf der ersten Aufnahme (vor der Behandlung) – und das nach nur 8 Minuten!
Häufige Fragen:
Unser Körper besteht aus einem riesigen Netzwerk an kleinsten Blutgefäßen, die teilweise 4x dünner als ein Haar sind (daher das Wort „Mikro“). Die Mikrozirkulation ist der Teil unseres Blutkreislaufs, welcher jede einzelne Körperzelle über einen geregelten Blutfluss mit dem notwendigen Sauerstoff und Nährstoffen versorgt. Zu ihren Aufgaben gehört es außerdem, Stoffwechselendprodukte wie Kohlendioxid, welche durch die Zellarbeit anfallen, abzutransportieren. Mikrozirkulation besteht aus verschiedenen Strukturen: aus kleinsten Blutgefäßen (Arteriolen, Kapillaren, Venolen), initialen Lymphgefäßen (am Anfang stehend) und dem interstitiellen Raum (Raum zwischen Blutgefäßen, Zellen und Lymphgefäßen).
Wissenschaftliche Erkenntnisse belegen, dass die Gesundheit und Leistungsfähigkeit eines Menschen entscheidend von einer funktionierenden Mikrozirkulation abhängen. Bei allen höheren Lebensformen werden die Versorgung der Zellen mit Sauerstoff und Nährstoffen, die Entsorgung von „Abfallprodukten“, lebenswichtige Informationen über Hormone und Botenstoffe, die Immunabwehr und vieles mehr über die Durchblutung reguliert. Die Leistungs- und Funktionsfähigkeit jeder einzelnen Körperzelle, der Muskeln, Gelenke, Organe, Drüsen, des Immunsystems etc. hängen von einer optimalen Ver- und Entsorgung über die Mikrozirkulation ab.
Die Magnetfeldtherapie (physikalische Gefäßtherapie) kann eine lindernde Maßnahme für Beschwerden sein, die durch eine gestörte Mikrozirkulation infolge einer schwachen Vasomotorik hervorgerufen werden, gleichzeitig damit auftreten oder Komplikationen verursachen. Das Ziel der Magnetfeldtherapie ist es, die eingeschränkte Kontraktionsfrequenz kleinerer und sehr kleiner präkapillärer arterieller Blutgefäße (< 100 μm) zu steigern. Dadurch kann die Blutverteilung sowie der Blutfluss im kapillaren Netz der Mikrozirkulation verbessert und der Heilungsprozess angeregt werden. Das ist die Grundlage dafür, dass sowohl schulmedizinische Therapien als auch Naturheilverfahren besser wirken können.
Die Ursachen für Durchblutungsstörungen, Leistungsschwäche, vorzeitiges Altern und Krankheiten bei Menschen in den Industriestaaten sind vor allem auf ihre Lebensweise zurückzuführen. Besonders Bewegungsmangel, Übergewicht / Fehlernährung, psychischer Stress und zunehmende Umweltbelastungen stellen dabei Risikofaktoren dar, welche zu einer Beeinträchtigung der Durchblutung führen und damit die Hauptursachen für vorzeitiges Altern und die Entstehung von Krankheiten sind.
… Sie setzt an einigen der wichtigsten Ursachen von Krankheiten (Mangeldurchblutung und Energiemangel) an, ohne von dieser Störung eingeschränkt zu sein, und kann zu einer gesteigerten Lebensqualität sowie mehr Leistungsfähigkeit beitragen.
… Sie kann vielfältige, naturgegebene Selbstregulationsmechanismen (breites Wirkspektrum) unterstützen.
… In langjähriger Anwendung traten keine gesundheitsgefährdenden Nebenwirkungen auf.
… Sie wird zur Leistungssteigerung, schnelleren Regeneration nach körperlicher und/oder geistiger Belastung, zur Gesundheitsvorsorge, Behandlung von Krankheiten und zur schnelleren Wund- sowie Knochenheilung eingesetzt.
… Sie ist mit jeder anderen Behandlungsmethode einfach zu kombinieren und eignet sich zur Unterstützung schulmedizinischer Therapieverfahren, weil sie die Wirkung von Medikamenten unterstützen und ggf. zur Reduktion der Medikamentendosis führen kann.
… Sie zeigt oft noch Wirkung, wo herkömmliche Behandlungen keine Resultate mehr bringen (bei austherapierten Fällen).
… Ihre Wirkung auf eine eingeschränkte Mikrozirkulation ist in mehr als 15 Jahren konstanter Forschungs- und Entwicklungsarbeit sowohl theoretisch als auch praktisch wissenschaftlich belegt.
… Die Magnetfeldtherapiegeräte sind als medizintechnische Geräte geprüft, zugelassen und zertifiziert.
… Sie ist für Mediziner und Privatanwender gleichermaßen geeignet.
ANWENDUNGSGEBIETE DER MAGNETFELDTHERAPIE (GEFÄßTHERAPIE) IM ÜBERBLICK:
- Sie kann die Mikrozirkulation und Durchblutung verbessern
- Sie kann die Sauerstoff- und Nährstoffversorgung der Zellen verbessern
- Sie kann den Abtransport von Stoffwechselabfällen verbessern
- Sie kann eine schnellere Wundheilung und Zellregeneration fördern
- Sie kann das Immunsystems stärken
- Sie kann zu mehr Energie und Leistungsfähigkeit beitragen
- Sie kann die Organfunktionen und die Gewebegesundheit unterstützen
- Sie kann dabei helfen, Stress zu reduzieren
- Sie kann die Schlafqualität verbessern
- Sie kann als therapiebegleitende Maßnahme bei Erektionsstörungen helfen (NIE ohne Beratung & Behandlung durch einen Arzt!!)
Du möchtest mehr über die Magnetfeldtherapie (Gefäßtherapie) von BEMER erfahren?
Dann melde dich bei mir!
Du möchtest einen Erfahrungsbericht aus erster Hand?
Als Radsportler nutzt Thomas Riedel die Magnetfeldtherapie bereits seit vielen Jahren. Dank ihr konnte er seine sportlichen Leistungen deutlich verbessern. Seine Erfahrungen teilt er gern persönlich mit dir.
